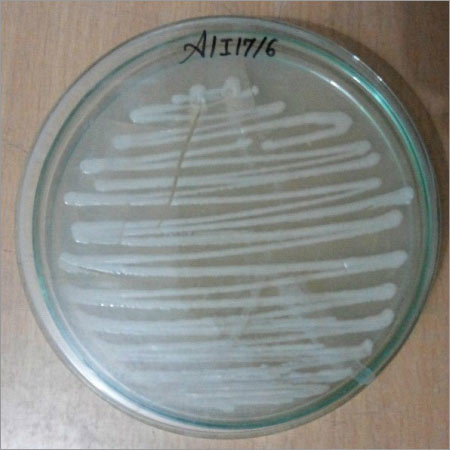
अज़ोस्पिरिलुम

ट्राइकोडर्मा विराइड
प्राइस: 5000.00 INR
(5000.00 INR + 0% GST)स्टॉक में
| प्रोडक्ट का नाम | Tricho |
| डिलीवरी का समय | 1महीने |
| मुख्य निर्यात बाजार | मिडल ईस्ट, पूर्वी यूरोप, ऑस्ट्रेलिया, दक्षिण अमेरिका, एशिया, उत्तरी अमेरिका, पश्चिमी यूरोप, मध्य अमेरिका, अफ्रीका |
| भुगतान की शर्तें | कैश इन एडवांस (CID) |
| मुख्य घरेलू बाज़ार | ऑल इंडिया |
विस्तृत जानकारी
| प्रोडक्ट का नाम | Tricho |
| डिलीवरी का समय | 1महीने |
| मुख्य निर्यात बाजार | मिडल ईस्ट, पूर्वी यूरोप, ऑस्ट्रेलिया, दक्षिण अमेरिका, एशिया, उत्तरी अमेरिका, पश्चिमी यूरोप, मध्य अमेरिका, अफ्रीका |
| भुगतान की शर्तें | कैश इन एडवांस (CID) |
| मुख्य घरेलू बाज़ार | ऑल इंडिया |
कंपनी का विवरण
व्यापार के प्रकार
निर्माता, निर्यातक, आयातक, वितरक, आपूर्तिकर्ता, थोक विक्रेता
कर्मचारी संख्या
10
स्थापना
2012
कार्य दिवस
सोमवार से शुक्रवार
भुगतान का प्रकार
अग्रिम नकद (सीआईडी)
Certification
AN ISO 9001:2015
विक्रेता विवरण
नेचर ाग्रोसरे एंड रिसर्च प्राइवेट लिमिटेड
रेटिंग
4
नाम
योगेंद्र सिंह
पता
सर्वे नो- २५३/२ सर कंपाउंड, लसूड़िया मोरी, इंदौर, मध्य प्रदेश, 452010, भारत
गलत विवरण की रिपोर्ट करें
संबंधित उत्पाद
कैप्टन संपर्क कवकनाशी अनुप्रयोग: कीट नियंत्रण
Price - 2150 INR
MOQ - 100 Kilograms/Kilograms
सत्यम बायोटेक
इंदौर, Madhya Pradesh
ओनेंथॉल बिसल्फेट ऑर्गेनिक फफूंदनाशक 98% आवेदन: औद्योगिक
Price - 500 INR
MOQ - 500 Kilograms/Kilograms
सूर्य एग्रीटेक्नोलोग्य
इंदौर, Madhya Pradesh
जैव कवकनाशी अनुप्रयोग: कृषि
Price - 200 INR
MOQ - 100 Kilograms/Kilograms
ट्रूबा इंडस्ट्रीज
इंदौर, Madhya Pradesh
कार्बेन्डाजिम 12% मैनकोज़ेब 63% Wp फफूंदनाशक तरल
MOQ - 100 Liter/Liters
नोवा इंटरनेशनल
इंदौर, Madhya Pradesh
भूकेयर कॉन्टैक्ट फंगसाइड एप्लीकेशन: ऑर्गेनिक फर्टिलाइजर
Price - 500 INR
MOQ - 100 Pack/Packs
भूकारे फ़ूडच्यं प्राइवेट लिमिटेड
इंदौर, Madhya Pradesh
बायो ऑर्गेनिक फफूंदनाशक पाउडर अनुप्रयोग: कृषि
MOQ - 100 Kilograms/Kilograms
नेचर ाग्रोसरे एंड रिसर्च प्राइवेट लिमिटेड
इंदौर, Madhya Pradesh